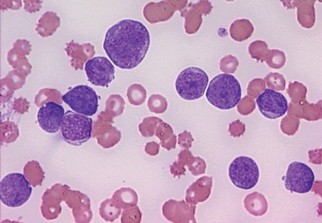

Le traitement de la leucémie myéloïde chronique, un cancer des globules blancs, est de mieux en mieux traité. Aujourd’hui, 90% des patients peuvent espérer en guérir.Il existe plusieurs formes de leucémies qui sont réparties en deux catégories : les leucémies aiguës et les leucémies chroniques. Les leucémies aiguës sont des maladies d’évolution rapide qui mettent en jeu la vie des patients à court terme en l’absence de traitement.
Dans les leucémies chroniques, les cellules qui prolifèrent ont terminé leur maturation, ce qui explique leur évolution plus lente. Parmi les leucémies chroniques, la leucémie myéloïde était souvent synonyme de parcours du combattant pour les patients, et l’issue n’était pas forcément positive. Or, comme s'enthousiasme le Pr Philippe Rousselot, professeur d'hématologie à l'université Versailles-Saint-Quentin-en-Yvelines, dans un entretien accordé au Figaro, « la leucémie myéloïde chronique peut désormais être traitée dans 90 à 95 % des cas».
Environ 8 000 personnes en France sont atteintes de leucémie myéloïde et 700 nouveaux cas sont découverts chaque année. Cette forme de cancer du sang touche plus les hommes que les femmes, principalement après 50 ans.
Dans de nombreux cas, sa découverte est fortuite et se fait à l'occasion d'une analyse de sang qui révèle un trop grand nombre de globules blancs. Le diagnostic définitif repose ensuite sur des analyses qui permettent de déterminer à quel stade la maladie a évolué et quel est le pourcentage de cellules immatures dans le sang. Neuf fois sur dix, ce taux est inférieur à 6%, ce qui qualifie la maladie de chronique, sans symptômes.
« Mais aujourd’hui, 90 à 95% des patients atteints par cette maladie vont obtenir un traitement qui leur convient», insiste le Pr Rousselot. Seul inconvénient : ces traitements doivent être suivis au minimum pendant plusieurs années, parfois à vie.
Et les échecs sont souvent dus au fait que le patient finit par se lasser d’un traitement qui dure aussi longtemps. Le prochain défi des médecins et des chercheurs sera donc de permettre d'arrêter le traitement lorsque la rémission moléculaire sera atteinte.















